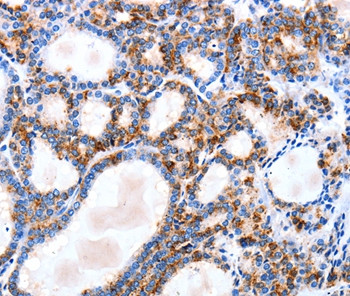
IGSF6 Antibody in Immunohistochemistry (Paraffin) (IHC (P))

Search
Invitrogen
IGSF6 Polyclonal Antibody
{{$productOrderCtrl.translations['antibody.pdp.commerceCard.promotion.promotions']}}
{{$productOrderCtrl.translations['antibody.pdp.commerceCard.promotion.viewpromo']}}
{{$productOrderCtrl.translations['antibody.pdp.commerceCard.promotion.promocode']}}: {{promo.promoCode}} {{promo.promoTitle}} {{promo.promoDescription}}. {{$productOrderCtrl.translations['antibody.pdp.commerceCard.promotion.learnmore']}}

Please note: We are reviewing Western blot images included in the antibody testing data in our catalog, including those provided by third parties. Unless expressly labeled or annotated as “raw-unedited”, Western blot images included in the antibody testing data in our catalog may have been edited, optimized or otherwise adjusted for presentation.
产品信息
PA5-50227
种属反应
宿主/亚型
分类
类型
抗原
偶联物
形式
浓度
规格
纯化类型
保存液
内含物
保存条件
运输条件
RRID
产品详细信息
The antibody detects endogenous levels of total IGSF6 protein.
靶标信息
IGSF6 (DORA), a novel member of the immunoglobulin superfamily (IGSF) from human and rat expressed in dendritic and myeloid cells. Using a probe from the open reading frame of the rat cDNA, we isolated a cosmid which contains the entire mouse gene. By comparative analysis and reverse transcriptase polymerase chain reaction, we defined the intron/exon structure and the mRNA of the mouse gene and, with respect to human BAC clones, the human gene. The genes span 10 kb (mouse) and 12 kb (human), with six exons arranged in a manner similar to other members of the IGSF. All intron/exon boundaries follow the GT-AG rule. Expression of the mouse Igsf6 gene is restricted to cells of the immune system, particularly macrophages. Northern blot revealed a single mRNA of 2.5 kb, in contrast to the human gene which is expressed as two mRNAs of 1 and 2.5 kb. The human and mouse genes were localized to a locus associated with inflammatory bowel disease. Analysis of the flanking regions of the Igsf6 gene revealed the presence of an unrelated gene, transcribed from the opposite strand of the DNA and oriented such that the Igsf6 gene is encoded entirely within an intron. An identical organization is seen in human.
仅用于科研。不用于诊断过程。未经明确授权不得转售。
篇参考文献 (0)
生物信息学
蛋白别名: IgSF6; Immunoglobulin superfamily member 6; Protein DORA
基因别名: DORA; IGSF6
Entrez Gene ID: (Human) 10261